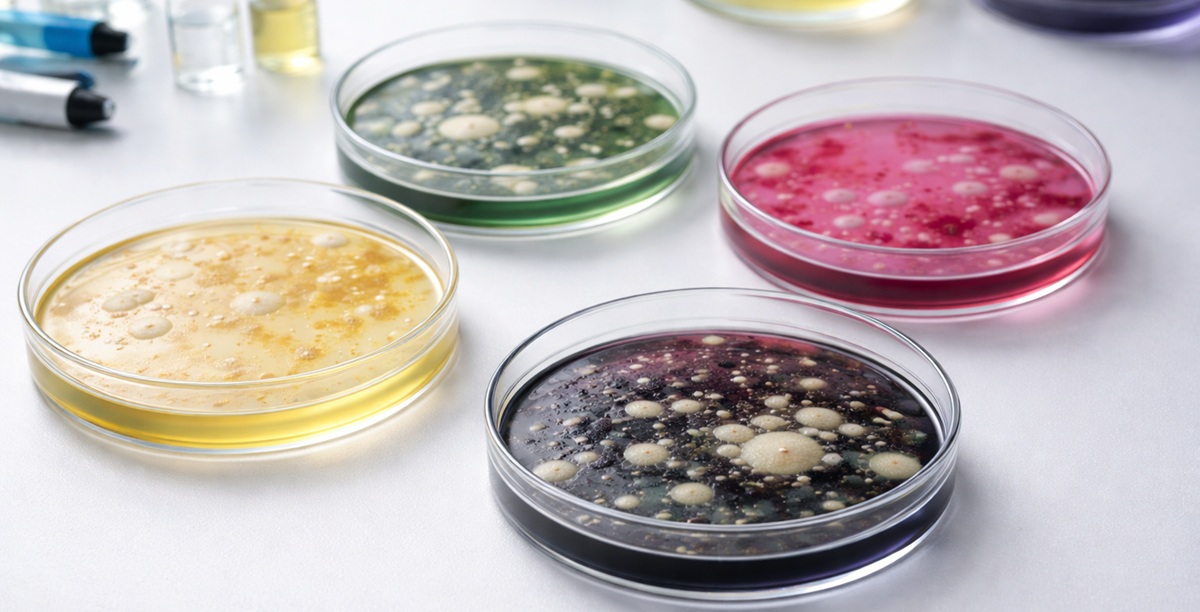

Inscripciones Online
Completa la solicitud online y accede a este y muchos otros contenidos y servicios
DÍA INTERNACIONAL DE MUJER
¡La oportunidad profesional que estabas buscando!
¿Puedo asociarme siendo estudiante?
¡Tú puedes ser socio!
Solo es necesario poseer una titulación universitaria de una carrera relacionada con las ciencias de la salud para solicitar ser asociado. Completa la solicitud online ahora haciendo clic en el botón.
Prensa & Noticias
Bolsa de trabajo
Asociate y accede a las mejores de ofertas laborales que se ajustan a tu perfil profesional.
- Filtros avanzados
- Alertas personalizadas
- Listados por sectores
- Contacto con empleadores
Nuestro Equipo

Ana Andujar
Sección Catalana
vocal de Investigación Clínica

Yolanda Lara
Sección Centro
Vocal Investigación Clínica




Ana Aguilera
Junta de Gobierno, Sección Centro
Secretaria



Xavier Riera
Sección Catalana
Vocal Alimentación y Cosmética

Bárbara Burgos
Sección Centro
Vocal Farmacovigilancia


Eva Pascual
Junta de Gobierno, Sección Catalana
Junta de Gobierno
Vicepresidenta 1ª
Sección Catalana
Presidenta

Mercedes Carrera
Sección Catalana
Secretaria

Carmen Aguilera
Junta de Gobierno, Sección Centro
Junta de Gobierno
Vicepresidenta 2ª
Sección Centro
Presidenta

Ángel García
Junta de Gobierno, Sección Centro
Tesorero


Carmen García
Sección Centro
Vocal Universidades

Santiago Almazán
Sección Centro
Vocal Acceso al Mercado


Carolina Rubio
Junta de Gobierno, Sección Centro
vocal de Junta de gobierno
vocal de Garantía de calidad, Fabricación y Control de calidad



Ana Mª López
Junta de Gobierno
Presidenta

Cristina Agudo
Junta de Gobierno, Sección Centro
Vocal Cosmética y Seguridad Alimentaria